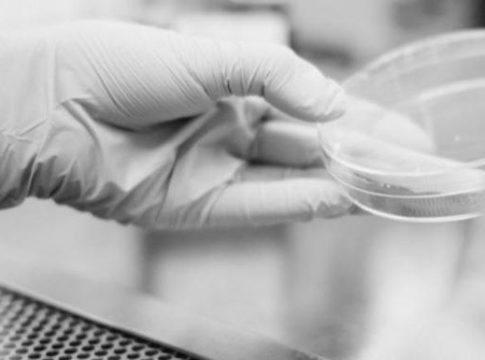
Qué es una PCR Qué es una PCR

Igenomix lanza "el primer test PCR de saliva para la detección de la Covid-19", cuyo objetivo es "facilitar la extracción al ciudadano que, a partir de ahora, podrá recoger su propia muestra él mismo, cómodamente desde casa, y prevenir así los riesgos asociados a los desplazamientos".
"Este test está destinado a la detección cualitativa del ácido nucléico del SARS-CoV-2 en muestras del tracto respiratorio superior. Es una prueba PCR que puede ser recogida fácilmente por el propio paciente, depositando un poco de saliva en un recipiente que le facilitamos cuando recibe la caja con el test en su domicilio", explica, en un comunicado, el director de Marketing de Igenomix, Gonzalo Echavarría.
Desde la firma valenciana recalcan que a partir de ahora "no será necesario desplazarse a un centro médico o de extracción para someterse a una PCR que confirme o descarte la infección por Covid-19". El nuevo test de Igenomix se solicita por internet y se recepciona "en muy pocas horas en el domicilio", añaden.
La caja contiene las instrucciones de recogida y un pequeño recipiente donde el paciente puede depositar la saliva, después de haber guardado un 'microayuno' de 30 minutos.
Sellado el recipiente donde se ha depositado la saliva e introducido de nuevo en la caja, la prueba está lista para ser recogida por un mensajero de Igenomix, que se encarga de llevarla al laboratorio central para su procesado.
RESULTADOS EN 24 HORAS
"Los resultados de este nuevo test PCR COVID19 en saliva, estarán disponibles en 24 horas, a partir de la recepción de la muestra en nuestros laboratorios. El paciente recibirá entonces un correo electrónico con el resultado de su test", concluye Echavarría.
La biotecnológica valenciana ha procesado más de 120.000 test desde el inicio de la pandemia. Una de las "preocupaciones" de Igenomix es poder ofrecer una "mayor accesibilidad a este tipo de test". En este sentido, desde la compañía se han puesto en marcha diferentes iniciativas como la del 'drive thru', que ofrece a los usiarios testarse sin bajar del coche en algunos parkings de grandes ciudades del mundo.